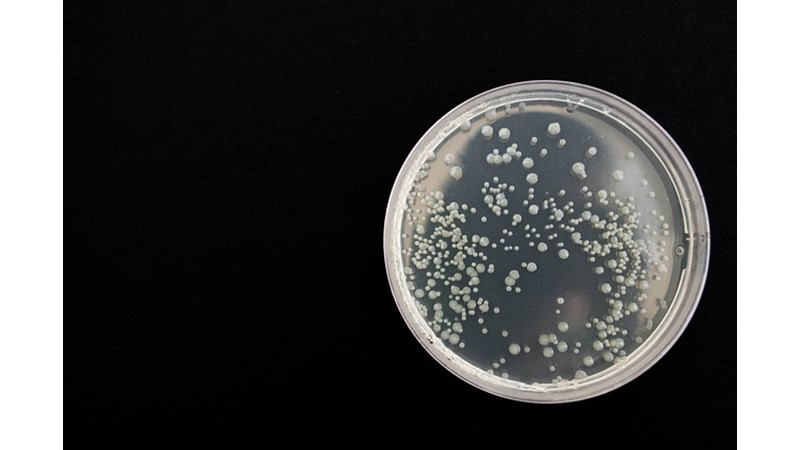

Bakteriler beş duyudan dördüne sahip
Bu son keşif bakterilerin beş duyudan dördüne sahip;
— Işığa reaksiyon verme-görme,
— Temasa bağlı gen anlatımı-dokunma
— Çevredeki kimyasallara ve toksinlere doğrudan temas yoluyla tepki gösterme-tatma
— Havadaki kimyasallara tepki gösterme-koklama) olduğunu gösteriyor.
Nitrojenin en basit kaynaklarından olan amonyak, bakterilerin çoğalması için de önemli bir besin. Araştırma ekibi toprakta yaygın olarak bulunan rakip iki bakteriyi (Bacillus subtilis ve B. licheniformus) kullanarak, her iki türün de havadaki amonyağa tepki olarak biyofilm oluşturduğunu ve iki bakteri kolonisi arasındaki mesafe arttıkça bu tepkinin de azaldığını tespit etti.
Dove Deniz Laboratuvarı’ndan projenin danışmanı Prof. Grant Burgess, bu çeşit bir tepki hareketinin tetikleyicisini anlamanın çok büyük önem taşıdığını söylüyor. Koku duyusunun maya ve cıvık mantarlar gibi birçok organizmada gözlendiğini, fakat kendi çalışmalarının ilk defa basit bakterilerde koku duyusunun varlığını gösterdiğini ekliyor. Bunun henüz yeni bir gözlem olduğuna ve hâlâ yapılması gereken çok şey olduğuna dikkat çekiliyor. Fakat karmaşık bakterilerin birbirleriyle iletişim kurmak için kullandığı yolların sayısının nasıl arttığını göstermesi açısından da önemli bir adım olduğunu söylüyor Prof. Burgess. Bakteriyel enfeksiyonların her yıl milyonlarca insanı öldürdüğünü ve bakteri düşmanlarımızın birbirleriyle nasıl iletişim kurduklarını keşfetmenin, aramızdaki savaşı kazanmada önemli bir adım olduğunu belirten Prof. Burgess, bu araştırmanın bugüne kadar bakterilerin iletişim biçimlerinin bilinmeyen yönleri için ipucu verdiğini söylüyor.


 probiyotik
probiyotik

Yorumlar
Bakteriler o kadar da boş değilmiş
güzel içerik
Yorum yazmak için lütfen giriş yapınız